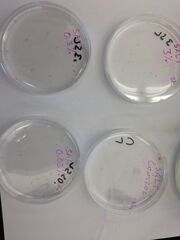

Uploads by Kirk Blackmoore
From OpenWetWare
Jump to navigationJump to search
This special page shows all uploaded files.
| Date | Name | Thumbnail | Size | Description |
|---|---|---|---|---|
| 03:52, 11 March 2014 | Zebrafish KB.JPG (file) | |
2.02 MB | |
| 00:21, 27 February 2014 | Invertebrates krb.jpeg (file) |  |
1.9 MB | |
| 00:20, 27 February 2014 | We up.jpeg (file) |  |
2.19 MB | |
| 00:19, 27 February 2014 | Earthworm.jpeg (file) |  |
2.19 MB | |
| 00:18, 27 February 2014 | Flatworm krb.jpeg (file) |  |
2.07 MB | |
| 00:16, 27 February 2014 | Flatworm.jpeg (file) |  |
2.05 MB | |
| 22:44, 26 February 2014 | Fungus Krb.JPG (file) |  |
747 KB | |
| 22:23, 26 February 2014 | Vascularization.jpeg (file) |  |
1.39 MB | |
| 22:21, 26 February 2014 | Tree doe.jpeg (file) |  |
3.53 MB | |
| 22:19, 26 February 2014 | Transect KRB.jpeg (file) |  |
3.32 MB | |
| 22:14, 26 February 2014 | Lily.jpeg (file) |  |
1.48 MB | |
| 19:25, 9 February 2014 | Agar.JPG (file) |  |
662 KB | |
| 18:50, 9 February 2014 | Didinium.JPG (file) |  |
35 KB | |
| 18:46, 9 February 2014 | Bursaria.JPG (file) |  |
52 KB | |
| 04:41, 9 February 2014 | Lab 2 draw.JPG (file) |  |
808 KB | |
| 21:00, 31 January 2014 | AU Sec1 Volvocine.jpg (file) |  |
625 KB | |
| 20:51, 31 January 2014 | Volvocine.JPG (file) |  |
625 KB |